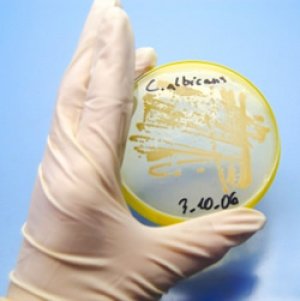
кандидоз и аутизм

Биомедицинское лечение аутизма. Антикандидозная и антибактериальная терапия: показания, препараты
Latest posts by Lady Venus (see all)
- Как стать востребованным косметологом? - 30.11.2021
- Как сделать, чтобы ноги не пахли - 06.07.2021
- Выбираем часы в подарок жене - 28.05.2021
Для лечения аутизма ребенка биомедицинскими методами, помимо обогащения организма витаминами и минералами, и диетотерапии при аутизме, применяется антикандидознуая, антибактериальная и антипаразитная терапия аутизма, с поддержкой иммунной системы аутичного ребенка. Какая связь у грибов кандида и аутизма, причем тут бактерии и паразиты, и зачем нужны такие методы?
Сейчас мы рассмотрим именно эти вопросы, а о том, какая витамино- минералотерапия необходима аутичным деткам, что означает диетотерапия при аутизме, и какой вклад в лечение аутизма ребенка оказывает выведение из организма тяжёлых металлов, вы можете прочитать в статьях:
«Биомедицинское лечение аутизма. Питание при аутизме: витамины, диеты без глютена, казеина и сои»,
«Биомедицинское лечение аутизма. Хелирование, как метод лечения аутизма. Детоксикация при аутизме».

- • АНТИКАНДИДОЗНАЯ ТЕРАПИЯ ПРИ АУТИЗМЕ
На первый взгляд, сочетание понятий грибки кандида и аутизм – совершенно нелепо, тем не менее, как подтверждает современная медицина, у его существования есть смысл.
• Кандидоз и аутизм: какая связь?
Сегодня уже всем очевидно, что кандиды содержат и продуцируют токсичные вещества, которые способны нарушать не только работу иммунной системы человека, но и его головного мозга. Много таких токсинов является не чем иным, как спиртами, производящимися дрожжевыми клетками в кишечнике из сахаров пищи. Одним из этих токсичных «сахарных спиртов» является арабинитол — сильный нейротоксин. В США уже сегодня есть возможность провести тесты на наличие данных спиртов в крови, что, по мнению некоторых ученых, особенно важно, если у пациента имеются нервно-психические проблемы или аутизм.
Несмотря на то, что связь таких явлений, как кандидоз и аутизм является новым и пока еще спорным предположением, уже имеются исследовательские подтверждения того, что в моче аутистов встречаются аномальные уровни метаболитов. А именно, существенно превышен уровень содержания в моче винной (виннокаменной) кислоты, чем у здоровых деток (у первых детей, принимавших участие в эксперименте, он был выше в 600 раз). Как известно, винная кислота – общепризнанный токсин, поэтому и появилась теория, что она провоцирует симптомы аутизма. Учитывая то, что эта кислота в организме человека не вырабатывается, ее единственный источник — это дрожжи кандида. Соответственно, если подавить размножения в кишечнике дрожжей, то это может привести к снижению поведенческих нарушений, которые характерны для аутизма. Лечение аутизма ребенка противогрибковым антибиотиком нистатин закончилось довольно успешно и на сегодня день тысячи деток с аутичными расстройствами были пролечены именно таким образом, а хороший клинический эффект, по свидетельствам исследователей составил 80-90 процентов случаев. Тем не менее, масштабных клинических испытаний взаимосвязи кандидоз и аутизм не проводилось. Хотя и лечение аутизма ребенка данным методом выдержало испытание временем, и сегодня многие доктора его используют и рекомендуют.
Сегодня доволь часто проводится антикандидозная терапия при аутизме с одновременной коррекцией в питании. Диета для детей аутистов назначается менее жесткая, хотя бы потому, что соблюдать ее трудно, учитывая немалые ограничения в пище по аллергическим показателям и самостоятельный отказ аутистов от некоторых продуктов, ввиду поведенческих патологий. Кроме того, на счет того следует ли абсолютно исключать из питания детей при аутизме молоко и дрожжевые продукты, единого мнения не существует, впрочем как и согласия в вопросе, как долго нужно придерживаться ограничительной диетотерапии при аутизме. Как правило, назначают такую диету для детей аутистов по обстоятельствам, от месяца до полугода.
• Антикандидозная терапия при аутизме: анализы и показания
- 1. Анализ стула аутичного ребенка, определяет наличие в организме аэробных грибков, однако негативный результат анаэробные грибки не исключает. Антикандидозная терапия при аутизме противогрибковыми средствами назначаться желательно должна после проведения анализов на чувствительность грибков в отношении тех или иных противогрибковых препаратов.
- 2. Анализ мочи аутичного ребенка на органические кислоты может помочь по косвенным признакам определить разрастание грибковой инфекции и ее уровень, а также наличие анаэробной инфекции. Наличие разросшейся грибковой инфекции могут подтвердить и увеличенные уровни бета-кетоглютарата, винной кислоты и цитрамалата.
• Антикандидозная терапия при аутизме: лечение аутизма ребенка
В последнее время, люди все чаще обращаются к нетрадиционным методам терапии, в том числе, если это лечение аутизма ребенка. За прошедшие десятилетия привычные противогрибковые средства, типа нистатин, начинают, мало по малу, впадать в немилость. Все чаще практикующие врачи обращаются к природным натуральным средствам лечения. Одним из таких является Saccharomyces boulardii — это естественно растущий грибок, который обладает способностью убивать другие грибковые инфекции. Еще одно немаловажное преимущество – как только прекращается его прием, сам он естественным образом исчезает из кишечника. Данное средство продается без рецепта и имеет эффективность противогрибковых медикаментов.
Но наиболее популярными, благодаря своей эффективности, являются пробиотики при аутизме в качестве борцов с появлением кандида. Они представляют собой специально культивируемые штаммы бактерий, которые идентичны тем, что заселяют наш кишечник в норме, способные удерживать под контролем дрожжи рода Candida Albicans. Пробиотики при аутизме назначают, когда рост дрожжей подавлен при помощи диеты или лекарственных средств, для окончательного восстановления микрофлоры кишечника.
Среди них главные — это лактобактерии и бифидобактерии, наделенные свойствами, не просто конкурировать с вредоносными дрожжами за жизненное пространство, также они увеличивают в кишечнике кислотность, создавая этим наименее благоприятные условия для размножения и роста кандида. Принимают пробиотики при аутизме либо в капсулах в сухом виде, либо в виде йогурта, что делает подобную терапию максимально удобной, просто включив пробиотики в питание детей при аутизме.
• Антикандидозная терапия при аутизме: медикаменты
НИСТАТИН. Выпускается в виде порошкового препарата, либо медицинского раствора на основе стевии. Применение нистатина предполагается частое — в день до 4-6 раз. Довольно много грибковых инфекций к нистатину устойчивы, поэтому для достижения требуемого результата обычно нужны более сильные противогрибковые средства.
Побочные эффекты: препарат не токсичен, так как в системный кровоток не всасывается, оставаясь в кишечнике. Однако в результате реакции «вымирания» происходит выделение токсинов и, как правило, к временному ухудшению самочувствия, отражающегося в начале лечения на поведении и усилении поноса. Минимизировать реакцию «вымирания» может помочь активированный уголь, посредствам абсорбирования токсинов и выведения их из организма. Рекомендуется давать до 4 капсул в сутки, избегая совместного принятия пищи или каких-то других медикаментов.
СИСТЕМНЫЕ ПРИТИВОГРИБКОВЫЕ СРЕДСТВА. Антикандидозная терапия при аутизме в качестве системных препаратов включает прием низорала (кетоконазола), дифлюкана (флюконазола), споранокса (итраконазола) или ламизила. При применении любого системного противогрибкового средства, обязательно необходимо проверять функцию печени, не менее одного раза в 3 месяца (обычно ухудшения исчезают после прекращения приема препаратов). Кроме того при использовании ламизила проверять следует и функционирование почек. Как правило, назначается 3-х недельный курс для лечения, с целью избежать токсичности печени, и по завершению проводят контрольные анализы.
• Продолжительность антикандидозной терапии
В действительности избавиться от грибковой инфекции довольно сложно. Понадобиться может очень длительное время применять противогрибковые средства, увеличивать дозировку, или одновременно использовать несколько средств сразу. Если у вашего ребенка склонность к дрожжевым инфекциям, то его лучше регулярно проверять на грибки. Терапия липоевой кислотой (аббревиатура ALA) или димеркаптосукциновой кислотой (аббревиатура DMSA), которая используется при лечении аутизма ребенка, может спровоцировать разрастание дрожжей, даже у деток, не имевших раньше этой проблемы.
- • АНТИБАКТЕРИАЛЬНОЕ ЛЕЧЕНИЕ АУТИЗМА
Также кишечник аутиста может быть перенаселенным вредоносными бактериями и, чтобы восстановить нормальную микрофлору, их необходимо будет устранить, применив антибактериальное лечение аутизма. Чаще им подвержены дети и взрослые, часто употреблявшие антибиотики.
• «Бактериальное» тестирование
Чтобы выявить наличие вредных бактерий в организме используют анализ мочи на органические кислоты. В случае высокого уровня дигидроксифенилпропионовой кислоты (аббревиатура DHHPA), подозревают разросшуюся Clostridia species.
Кроме того, имеется еще порядка 8 других показателей, обычно повышающихся при наличии в кишечнике каких-либо патологических бактерий, а также паразитирующих организмов.
• Антибактериальное лечение аутизма: медикаменты
БИОЦИДИН. Биоцидин является натуральным средством, позволяющим справиться с clostridia.
ГЕНТАМИЦИН ОРАЛЬНЫЙ. Назначают 5 раз в сутки на протяжении 3-х дней. Главное его преимущество в том, что в системный кровоток он не всасывается, поэтому осложнения и побочные эффекты встречаются крайне редко.
ФЛАГИЛ. Обычно Флагил назначают 2-недельным курсом.
ВАНКОМИЦИН ОРАЛЬНЫЙ. Назначают препарат 5 раз в сутки, курс лечения — 3 дня. В системный кровоток не всасывается, поэтому побочные эффекты встречаются крайне редко.
ИММУНОГЛОБУЛИН ОРАЛЬНЫЙ. Данным препарат появился недавно, он новый, но прошедший несколько исследований, которые показали, что он действительно помогает. Главное неудобство данной терапии — довольно высокая стоимость препарата.
- • АНТИПАРАЗИТНАЯ ТЕРАПИЯ АУТИЗМА
Существует небезосновательное мнение о необходимости очищения кишечника,людей страдающих аутизмом, от паразитов. Довольно многие паразиты часто присутствуют в норме в образцах стула, а именно: Balantidium coli Dientamoeba fragilis, Entamoeba hartmanni, Entamoeba coli и Endolimax nana. Другие являются более опасными, в частности таковыми являются лямблии (Giardia lamblia), и дизентерийная амеба (Entamoeba histolytica).
Необходимость антипаразитной терапии аутизма основана на способности паразитов вызывать иммунную реакцию организма на их присутствие, а это в свою очередь, может быть потенциальной причиной чувства вялости, недомогания, беспокойства, головной боли, ночной потливости, сыпи и массы других расстройств. Исследования показывают, что у части людей с аутизмом эти симптомы пропадают после того, как проводится антипаразитная терапия аутизма.
• Антипаразитная терапия аутизма: препараты
Для лечения назначают бактрим, септру (триметоприм/сульфаметоксазол). Суточная доза — 1 таблетка, плюс принятие гуматина (паромицина) четырежды в день. Курс терапии составляет 14 дней.
Также могут назначить Yodoxin трижды в день на протяжении двух недель, или метронидазол таким же курсом (дозировка в зависимости от веса больного).
Пробиотики при аутизме помогают заселить кишечник после антипаразитного лечения полезной микрофлорой.
Среди продуктов большое значение имеют следующие виды бактерий:
- 1. Лактобатерии — имеются в йогуртах, применять которые нельзя при безказеиновой диете для детей аутистов. Также продаются в виде препаратов.
- 2. Бифидобактерии можно получать в виде пищевых добавок.
- 3. Ферменты — очень эффективные источники полезных бактерий. Ферментированные продукты – «морской рис», чайный гриб, квашеная капуста, безмолочный кефир.
- • БЕЗДРОЖЖЕВАЯ ДИЕТА ДЛЯ ДЕТЕЙ АУТИСТОВ
Несмотря на то, что поступающие в организм с продуктами дрожжи, причиной грибковых инфекций не являются, они способны вызывать негативную иммунную реакцию у людей, которые уже чувствительны к дрожжевым продуктам питания. Кроме того, высокое содержание углеводов и сахара в рационе дает пищу для грибковых инфекций, их размножения, в то время как они уже заселились в организме, то есть усугубляет проблему.
• Диетическое питание детей при аутизме
Следует избегать пищи, которая приготавливается с использованием дрожжей. Кроме того не стоит употреблять ферментированные и выдержанные продукты (то есть продукты долгой выдержки, к примеру, выдержанные сыры, вина). Нежелательно употребление соков, сухих фруктов (помимо высокого содержания сахара в них, еще и наличие плесени возможно), приправ и соусов, грибов, а также витаминов группы B, поскольку они приготовлены на дрожжевой основе. Ну и конечно, сахар, и прочие углеводы – благоприятные составляющие для развития дрожжей в организме.
Вернуться на страницу «Методы лечения аутизма. Существующие способы лечебной коррекции аутизма» >>
Еще немного об аутизме и лечении аутизма ребенка: